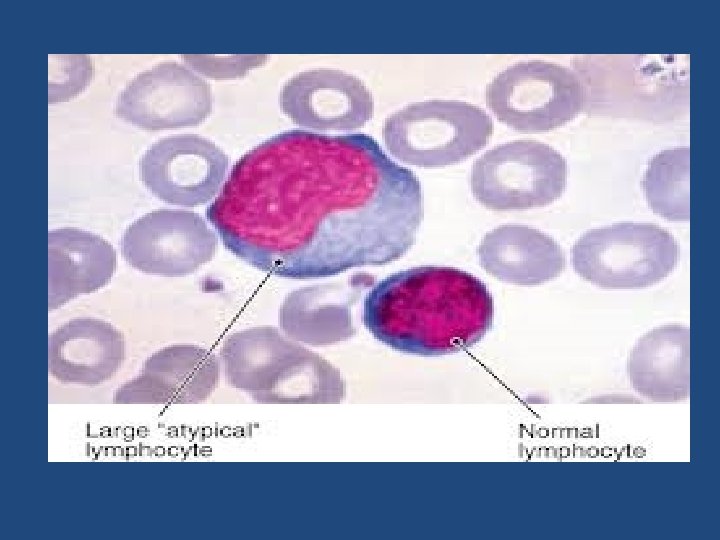

VIROLOGY HERPES VIRUSES DNA viruses Three Naked icosahedral











![Replication - Receptor on surface of cell [site of fibroblast growth factor]- the HSV Replication - Receptor on surface of cell [site of fibroblast growth factor]- the HSV](https://slidetodoc.com/presentation_image/f2cb004f83da582db9b4752fa23b922a/image-12.jpg)




















![• 2. Rapid diagnosis – Tzanck smear [Giemsa or Toluidine blue] multinucleated giant • 2. Rapid diagnosis – Tzanck smear [Giemsa or Toluidine blue] multinucleated giant](https://slidetodoc.com/presentation_image/f2cb004f83da582db9b4752fa23b922a/image-33.jpg)



![Treatment 1. Acyclovir [zovirax] – encephalitis and systemic disease of HSV-1 • Also useful Treatment 1. Acyclovir [zovirax] – encephalitis and systemic disease of HSV-1 • Also useful](https://slidetodoc.com/presentation_image/f2cb004f83da582db9b4752fa23b922a/image-37.jpg)
![2. Trifluridine topical [a nucleoside analogue] used for eye infection. 3. Penciclovir for orolabial, 2. Trifluridine topical [a nucleoside analogue] used for eye infection. 3. Penciclovir for orolabial,](https://slidetodoc.com/presentation_image/f2cb004f83da582db9b4752fa23b922a/image-38.jpg)

![Varicella Zoster [V-Z virus] Disease: Varicella–chickenpox –primary disease Zoster – Shingles – recurrent form. Varicella Zoster [V-Z virus] Disease: Varicella–chickenpox –primary disease Zoster – Shingles – recurrent form.](https://slidetodoc.com/presentation_image/f2cb004f83da582db9b4752fa23b922a/image-40.jpg)








![Zoster [shingles] – painful vesicles along the course of a sensory nerve of the Zoster [shingles] – painful vesicles along the course of a sensory nerve of the](https://slidetodoc.com/presentation_image/f2cb004f83da582db9b4752fa23b922a/image-49.jpg)





![Cytomegalovirus Diseases – Cytomegalic inclusion disease [especially congenital abnormalities] in neonates. • Pneumonia and Cytomegalovirus Diseases – Cytomegalic inclusion disease [especially congenital abnormalities] in neonates. • Pneumonia and](https://slidetodoc.com/presentation_image/f2cb004f83da582db9b4752fa23b922a/image-55.jpg)















![Treatment • Ganciclovir [Cytovene], Cidofovir [Vistide], Fomiversin [Vitravene] is used in the treatment of Treatment • Ganciclovir [Cytovene], Cidofovir [Vistide], Fomiversin [Vitravene] is used in the treatment of](https://slidetodoc.com/presentation_image/f2cb004f83da582db9b4752fa23b922a/image-71.jpg)


![Epstein Barr Virus [EBV] - • Named after Epstein and Barr Epstein Barr Virus [EBV] - • Named after Epstein and Barr](https://slidetodoc.com/presentation_image/f2cb004f83da582db9b4752fa23b922a/image-74.jpg)






![Pathogenesis and Immunity- • Infection in oropharynx [epithelium or lymphoid tissue? ] – Spread Pathogenesis and Immunity- • Infection in oropharynx [epithelium or lymphoid tissue? ] – Spread](https://slidetodoc.com/presentation_image/f2cb004f83da582db9b4752fa23b922a/image-81.jpg)

- Slides: 110
VIROLOGY HERPES VIRUSES
DNA viruses • Three Naked , icosahedral capsid DNA viruses arei. Parvo ii. Papova & iii. Adeno viruses-Maybe small size to large in size • Three enveloped families are i. Hepadna - including Hepatitis B ii. Herpes - both are enveloped & with icosahedral symmetry iii. Pox virus - Largest & with complex symmetry.
DNA enveloped Viruses 1. Herpes virus • Group has about eight important pathogen. • Are ubiquitous and cause disease in plants and animals and are of economic importance. • Cause spectrum of diseases • Have ability for latency • Have ability for periodic activation • Also a vesicular rash is common except in CMV & EB viral diseases.
Classification of Human Herpes Viruses
HSV 1 & 2 • These are distinguished by a. Antigenicity b. Location of lesion • Lesion of HSV-1 above waist, HSV – 2 below waist [abnormal behavior – may change location]
Diseases : • HSV-1 – Acute gingivo stomatitis. Recurrent herpes labialis – Cold sores. Keratoconjunctivitis Encephalitis. • HSV-2 - Genital herpes Neonatal herpes Aseptic meningitis
Properties • Morphology and structure of both are same. • Differentiation is by i. Restriction endonuclease patterns of the genomic DNA. ii. Using types specific monoclonal antisera iii. On chick embryo CAM type 2 strains form larger pocks resembling variola. iv. Types 2 strains replicate well in chick embryo fibroblast cells, while type 1 strains do so poorly.
v. The infectivity of type 2 is more temperature sensitive than that of type 1. vi. Type 2 strains are more neurovirulent in laboratory animals than type 1. vii. Type 2 strains are more resistant to antiviral agents like IUDR and cytarabine in culture. • Humans are natural host for both, but experimental infections can be transmitted into rabbits and mice.
Structure- • enveloped virion – 200 nm. • Envelope is derived from the modified host cell nuclear membrane. • Envelope has 8 nm long surface spikes. • Icosahedral capsid has 152 capsomers. • In between envelope and capsid is the amorphous tegument [structural viral proteins]. • Linear ds DNA
Replication - Receptor on surface of cell [site of fibroblast growth factor]- the HSV attaches here • Enter the cell • Uncoating • Genome DNA enter nucleus • Host cell RNA polymerase transcribes viral m. RNA • Translation into early non structural proteins in the cytoplasm
• 2 of the early proteins are thymidine kinase and DNA polymerase and are important because it is the site of action of acyclovir. • Viral DNA polymerase replicates the genomic DNA • Late protein synthesis begins • Late proteins transported to nucleus for virion assembly. • Virion gets its envelope by budding through nuclear membrane.
• Exits the cell via tubules or vacuoles to the exterior. • In latently infected cell – multiple copies of HSV-1 DNA are found in the cytoplasm of infected neurons. • Only few genes are transcribed and none of them are translated to proteins
Transmmission and epidemiology – • HSV-1 by saliva i. e. , direct contact. • HSV-2 by sexual contact. • The virus is easily inactivated at room temp. and drying, aerosol and Fomite spread are unusual means of transmission. • Special situation – oro- genital sex and auto inoculation is not uncommon mode - HSV-2 in oral cavity – 10 -20%. HSV-1 in infection of genital tract. • Transmission occurs actively if there is active lesion.
• It also occurs in asymptomatic cases where virus shedding is present. • Spread of HSV – 1 infection from oral secretions to other skin areas is an occupational hazard – dentists, respiratory care unit staff, wrestlers. • Laboratory acquired, Nosocomial out breaks in hospital and neonatal nurseries can occur. • Most primary HSV-1 is thought to occur in child hood because antibody is present in most of us. • HSV-2 – occurs during phase of sexual activity – antibody seen during that age.
Pathogenesis and Immunity • Initial site of infection – i. e. skin or mucous membrane, replication occurs, Migrate in neuron – latent in sensory ganglion cells • HSV-1 – trigeminal ganglia • HSV-2 - lumbar and sacral ganglia • Precise mechanism unknown – may be by lysogeny.
Reactivation – Induced by sunlight hormonal changes, trauma, stress, fever, U-V light. • Migrate down the neuron and replication in skin causing lesions. • Skin lesion – vesicle – [serous fluid with virus particles, cell debris]. • When rupture - vesicle release virions and can be transmitted to others
• Multinucleated giant cell [can be seen by Tzanck smear – fluid with toluidine blue] are typical at the base of lesion. • Also there is type specific immunity which can give some cross protection. • But immunity is incomplete because reinfection and reactivation can occur in presence of circulating Ig. G. • CMI is important for defense because if suppressed reactivation and severe disease. .
Clinical features – 1. Gingivostomatitis – children, fever, irritability and vesicular lesion in the mouth. These heal by 2 -3 weeks. But children may be asymptomatic also. 2. Herpes labialis – milder recurrent form of HSV Infection. • Also called fever blisters, cold sores – crops of vesicles seen. • Recurs frequently at the same site as previous one.
Gingivo-stomatitis Herpes labialis
3. Keratoconjunctivitis – Corneal ulcer, lesion of conjunctival epithelium scarring and blindness following recurrence.
4. Encephalitis– Temporal lobe involved frequently, high mortality severe neurologic sequelae with those who survive. 5. Herpetic whitlow - Pustular lesions of finger or hand. Usually in medical personal as a result of contact with patients lesion.
6. Disseminated – Oesophagitis, pneumonia usually seen in immunocompromised because of defect in the T cell.
HSV – 2 – • there is primary and recurrent infection. • 1. Genital – painful vesicular lesion – in both sexes. -Lesion in genital, anal area -Primary disease is severe and protracted than in recurrent disease -There is inguinal lymphadenopathy & fever
• Asymptomatic disease also seen – In men prostate, urethra In female cervix. • They are source for others. • Also many people have antibody to HSV-2 but no history of disease.
2. Neonatal herpes – Contact of vesicular lesions in birth canal during delivery. • Some cases have no visible lesions but still asymptomatic shedding of virus by mother can occur leading to child being infected. • Lesion in child – asymptomatic or mild local lesions or severe encephalitis or generalised disease.
• Prevention – Caesarian section advised if lesions are seen and positive viral culture of mother. • Both HSV-1 & 2 can cause severe neonatal infection after birth through carriers handling the child. • It does not cause congenital abnormalities alone. 3. Aseptic meningitis – by HSV-2 is usually mild, self limiting and with few sequelae following recovery.
Lab diagnosis 1. Isolation of virus – Fibroblast cell culture • CPE observed in 1 -3 days • Followed by fluorescent Ab staining of infected cells or detection of virus specific glycoprotein by ELISA.
• 2. Rapid diagnosis – Tzanck smear [Giemsa or Toluidine blue] multinucleated giant cell with Cowdry type A inclusion body. PAP stain also for HSV-2.
3. Rapid diagnosis of encephalitis – Fluorescent Ab staining of brain biopsy material, because culture is not useful as virus is rarely recovered. • DNA detection in CSF has replaced brain biopsy. • MRI scan detect encephalitis. • CSF shows lymphocytic pleocytosis, protein increase and sugar is normal.
4. Serology – Neutralization test used in diagnosis of primary infection • ELISA, CF - by observation of increase in Ab titer by paired sera examination. • Not useful in recurrent infection because adults already have circulating Ig and recurrences rarely cause rise in Ab titer.
Treatment 1. Acyclovir [zovirax] – encephalitis and systemic disease of HSV-1 • Also useful in recurrent or primary genital herpes- shortens the duration of lesion and reduces the extent of virus shedding. • In neonatal herpes by HSV-2 acyclovir can be used. • But mutants resistant to acyclovir seen • Foscarnet used in these cases.
2. Trifluridine topical [a nucleoside analogue] used for eye infection. 3. Penciclovir for orolabial, recurrent infection and in immunocompetent. • No drug treatment prevents recurrences • No effect on latent state. • Prophylactic acyclovir may help to suppress recurrences.
Prevention - • Avoiding contact of vesicular lesion or ulcer. • Recommended Caesarian section of mothers with genital herpes or positive viral culture.
Varicella Zoster [V-Z virus] Disease: Varicella–chickenpox –primary disease Zoster – Shingles – recurrent form.
Properties • VZV structurally and morphologically similar but antigenically different from HSV. • There is a single serotype- same virus causes both type of disease. • Humans are the natural host. • Replicative cycle – same as HSV.
Transmission and epidemiology • By respiratory droplets, direct contact with lesion. • Highly contagious disease of children– 90% population has Ab by 10 years of age. • World wide in distribution.
Pathogenesis and immunity • VZV infect mucosa of upper respiratory tract. • Enter blood skin • Vesicular rash [typical] having multinucleated giant cell and intranuclear inclusions in cells of base of lesion. • Recovery • Latency in dorsal root ganglion.
• Later in life especially if decrease in CMI, trauma etc. – reactivation • leads to vesicular skin lesion and also nerve pain. • Immunity following Varicella is life long • But Zoster can occur despite varicellar immunity. • Zoster can also occur once but frequency increases with age because of waning immunity.
Clinical feature- • Varicella – incubation period 14 -21 days. • Brief prodromal period of fever and malaise. • Followed by papulo vesicular rash • Crops of them on trunk and later spreading to head and extremities [centripetal rash] • Leads to papules, vesicles, pustules, crusting with severe itching.
• Usually varicella is mild in children but severe in adults. • In adults- severe symptoms, profuse rash, which may be sometimes hemorrhagic and bullous. • Complications in aged are varicella pneumonia and encephalitis, myocarditis, nephritis, cerebellar ataxia, meningitis, erythema multiforme. • Reyes syndrome – encephalopathy, liver degeneration is associated with VZV, influenza B virus especially with children given aspirin [unknown pathogenesis].
Zoster [shingles] – painful vesicles along the course of a sensory nerve of the head or trunk. • Pain lasts for weeks and post zoster neuralgia can occur and is very debilitating requiring ganglion surgery often as treatment. • It can also cause Bell’s palsy - Zoster of facial nerve.
• If there is tympanic involvement and Bell’s palsy -it is called Ramsy Hunt Syndrome. • In immunocompromised – systemic dissemination – pneumonia which is life threatening.
Laboratory diagnosis • Clinically chicken pox or shingles can be diagnosed • Presumptively by Tzanck smear – similar to HSV. • Definitive diagnosis by isolation in cell culture and use of specific antiserum to identify growth inside the cell line. • Rise in titer of antibody [paired sera] useful for diagnosis of chickenpox. • Not useful for zoster because antibody already present.
Treatment- Normal persons no need of antiviral therapy. • In immunocompromised Acyclovir can be given in systemic disease. • Foscarnet for resistant mutants. • In zoster for accelerating healing of lesion – Acyclovir, famciclovir, valacyclovir cure – but these do not cure latent state. • No effect on post zoster neuralgia which usually effects old people.
Prevention - • Acyclovir in immunocompromised useful. • VZIG – high titer of antibody virus – passive immunization. • VZV virus – live attenuated [varivax] prevent varicella – oka strain by Takahashi. • One dose for 1 -12 yrs, Teenagers 2 doses. • For zoster not useful
Cytomegalovirus Diseases – Cytomegalic inclusion disease [especially congenital abnormalities] in neonates. • Pneumonia and other diseases in immunocompromised • Heterophile negative mononucleosis in immuno competent.
Properties – Structurally & morphologically similar to HSV. • Antigenically different, single serotype. • Humans are natural host, animal strains do not infect. • Giant cells are formed hence the name
Replication – Similar to HSV. • Unique feature – some of the immediate early proteins are translated from m. RNAs brought into the infected cell from the original virion and not from the m. RNA synthesized in the newly infected cell.
Transmission and epidemiology • Variety of modes. • Early in life – across placenta, within birth canal, mothers milk • Common mode – saliva in children • Later in life – sexually – present both in semen and cervical secretion • Blood transfusion and organ transplants. • World wide in distribution – 80% of adults have antibody.
Pathogenesis and immunity • Cytomegalic inclusion disease. • Multinucleated giant cells and ‘owl’s eye’ inclusions.
• Many organs effected – congenital abnormalities results. • Commonly fetal infection is due to mother who contracts the virus during 1 st trimester and also this mother has no antibodies to neutralize the virus. • Infection in children and adults – asymptomatic except in immunocompromised.
• CMV enters latent state also in leucocytes and reactivated if decrease in CMI. • It can persist in kidneys for years. • CMV reactivation from cervical cells leads to infection during birth • CMV causes immunosuppression by inhibiting T cells. • Host defense is circulating antibody and CMI – this is important because its suppression leads to systemic disease.
Clinical findings • Approximately 20% of infected infants – cytomegalic inclusion disease – microcephaly, seizures, deafness, jaundice and purpura. • Hepatosplenomegaly is very common.
• Cytomegalic inclusion disease is one of the leading causes of mental retardation • Infected infants can continue to excrete CMV, especially in the urine, for several years.
• In immunocompetent adults, CMV can cause heterophile negative mononucleosis, which is characterized by fever, lethargy and the presence of abnormal lymphoctyes in peripheral blood smears. • Systemic CMV infections, especially pneumonitis and hepatitis, occur in a high proportion of immunosuppressed patients, eg. those with renal and bone marrow transplants.
• In AIDS patients, CMV commonly infects the intestinal tract and causes intractable diarrhea. • CMV also causes retinitis in AIDS patients, which can lead to blindness.
Laboratory diagnosis - The usual approach - culturing in special tubes called shell vials • Later immunofluorescent antibody used to detect growth • Diagnosis in 72 hours. • In cell cultures virus remains cell associated and CPE is slow [1 -2 weeks].
• Immunofluorescence with specific antibody will detect the virus in cultures. • If available, PCR-based assays that detect viral nucleic acids are also useful.
• Others - fluorescent antibody and histologic staining of inclusion bodies in giant cells - urine and in tissue [samples]. • The inclusion bodies are intranuclear and have an oval owls eye shape. • A 4 fold or greater rise in antibody titre is also diagnostic. • PCR based assays for CMV DNA or RNA in tissue or body fluids, such as spinal fluid, are also very useful. • Ig. M in serum by ELISA – can also be employed.
Treatment • Ganciclovir [Cytovene], Cidofovir [Vistide], Fomiversin [Vitravene] is used in the treatment of CMV retinitis and pneumonia in patients with AIDS. • Fomiversin – antisense DNA approved for intraocular treatment of CMV retinitis [latest drug and the only antisense DNA approved for human use]. • Foscarnet is also good but many side effect. • CMV is resistant to acyclovir.
Prevention • No vaccine • Ganciclovir can suppress progressive retinitis in AIDS – so prophylactic drug. • Isolation of infants shedding virus in urine • Blood transfusion to new born or to anyone should be CMV negative.
• As for as possible CMV antibody negative donors or organs should be used to transplant to antibody negative individuals requiring transplantation.
Epstein Barr Virus [EBV] - • Named after Epstein and Barr
• They observed the virus under electron microscope from cultures of lymphoblasts derived from Burkitt’s lymphoma. • It is implicated in Burkitt’s lymphoma, other B cell lymphomas, nasopharyngeal carcinoma.
• It is also associated with a whitish nonmalignant lesion on the tongue called hairy leukoplakia – especially in AIDS patients. • Commonly it causes infectious mononucleosis [IM] or kissing disease or glandular fever commonly in teenagers.
Important properties- • EBV is structurally and morphologically identical to other herpesvirus but is antigenically different. • Has a VCA antigen - it is used most often in diagnostic tests. • The early antigens [EA] produced prior to DNA systhesis. • EB DNA – nuclear antigen located in the nucleus bound to chromosomes. • All these help in diagnosis.
Others – Lymphocyte determined membrane antigen. Viral membrane antigen. • Neutralizing activity is directed against viral membrane antigen. • EBV replicates in the nasopharyngeal epithelial cells, salivary glands [Parotids] • Lyses the cells and are released in the saliva • When B cell is infiltrated it is also a target and gets infected. • Here latency is seen – forms a hybrid with B cell genome.
• Multiple copies of EBV DNA is found in cytoplasm of infected B cell. • Some of these genes are transcribed and only a subset of them is translated into proteins. • The latently infected cells can also be activated – B cell then can secrete Ig. M. • It has glycoprotein envelope gp 350/220 which mediates attachment to CD 21 receptor on susceptible cell – C 3 d receptor of the cell. • Humans are natural host.
Pathogenesis and Immunity- • Infection in oropharynx [epithelium or lymphoid tissue? ] – Spread to blood – Infect B lymphocyte – Cyto T cell attack infected B lymphocytes. • The T cells are atypical lymphocytes[Downey cells] seen in blood smear. • EBV can remain latent in B lymphocytes, few copies of EBV DNA integrated to cell genome. • Many copies of circular EBV DNA also found in the cytoplasm.
• Immune response to EBV – first Ig. M abntibody to VCA. • Ig. G antibody to VCA follows and persists for life. • Ig. M useful for diagnosis of acute infection • Ig. G – reveals prior infections. • Life long immunity to second episodes of IM is based on antibody to the viral membrane antigen. • Non specific - Heterophile antibodies are found.
• Heterophile means antibody that are detected by tests using antigen different from the antigens that induced them. (Paul Bunnel test) • Heterophile antibody of IM agglutinate sheep or horse RBC in laboratory [Forssman antibody is human serum can cross react with these antigens • So it is removed by adsorption with guinea pig kidney extract prior to agglutination].
• These antibody do not react with any component of EB virus. • Likely explanation is EBV infection modifies a cell membrane constituent so that it be comes antigenic and induces heterophile antibodies. • Usually heterophile antibody disappears within 6 months after recovery. • These are not specific for EBV as they can also be found in Hep B and serum sickness.
• Most shedding of virus occur in the oral cavity. So contact with saliva – kissing, contaminated eating utensils transmit. • Commonest world wide • During childhood most infection are asymptomatic • In adolescents it causes infectious mononucleosis or glandular fever. • In immunocompromised it has oncogenic potential and causes Burkitts lymphoma, naso pharyngeal carcinoma [China], thymic carcinoma [USA].
• Infectious mononucleosis – 15 -25 age group • Incubation period 4 -7 weeks. • Sore throat exudative tonsillitis, generalised lymphadenopathy, fever, malaise headache, sweating, fatigue, G-I discomfort. • Sometimes liver, spleen enlarged • A maculopapular rash follows treatment with ampicillin • This is due to immune complexes with antibody to Ampicillin.
• So contraindicated. • Lasts for 2 -3 weeks • Complication – Guillain Barre syndrome, Bells Palsy, meningo encephalitis, transverse myelitis, hemolytic anemia, thrombocytopenia, carditis, nephritis, pneumonia and splenic rupture.
• Infection in immunocompromised • a. X-linked lympho proliferative syndrome in male. (X-linked recessive immune deficiency) • There is deficiency in synthesizing interferons. • 50% boys die within a month due to sepsis, haemorrhages and rest of them develop or die from B cell lymphoproliferation usually associated with hypogammaglobulinemia and later lymphoma.
• b. EBV may cause progressive lymphoproliferative disease in transplant recipients, immunodeficient children and in AIDS patients.
EBV associated malignancies: • 1. Burkitt’s lymphoma – malignant B cell lymphoma seen in equatorial Africa, New Guinea where malaria is hyperendemic. • EBV is usually acquired early in life. • Malaria is the co-factor which potentiates the oncogenic potential of virus from B cell. • EBV genome DNA has been found as an episome in the African Burkitt’s, lymphoma cells. • The cells themselves do not produce virions. • But if grown, in vitro virions are produced.
2. Nasopharyngeal carinoma – Racial and geographical. • Seen in Chinese, Eskimos, Green landers. • Virions have been isolated form the malignant epithelial cells. 3. B cell lymphoma – Immunodeficient patients eg. HIV patients, transplant recepients may develop these lymphomas. 4. Oral hairy leukoplakia – In HIV patients, capsid of EBV seen in affected tissues. 5. Thymic carcinoma – seen in USA.
Lab diagnosis • Hematological approach – absolute lymphocytosis 10, 000 – 20, 000 cells/ cumm • Mainly lymphocytes and monocytes 20 -30% or more ‘atypical lymphs’. • These are large pleomorphic blasts with deeply basophillic vacuolated cytoplasm and globulated nuclei. • These are present in blood for 2 weeks or months [these are cyto - Tcell]
2. Immunological approach – Infectious mononucleosis is accompanied by heterophile aggluttinins. • These are Ig. M elicited by EBV infection. • These appear during acute phase in about 90% of patient sera. • Peak levels in 2 weeks after onset. • Titer decrease rapidly by 4 th week and not persists after 3 months.
• Agglutination of sheep or horse red cells by patients serum adsorbed with guinea pig kidney cell to remove Forssman antibody is basis of test. • Tube agglutination test – Paul Bunnel test. • Not useful to detect prior infection. • Monospot test – Commercial more sensitive, more specific, cheaper than tube agglutination test.
3. EBV specific antibody detection – Ig. M to EBV capsid antigen by ELISA, Indirect IF. • Detects upto 4 weeks of illness. • This Ig. M decrease by 3 months. • Useful for diagnosis of difficult cases. • Ig. G VCA antibody response – detects prior infection • Certains instances - Antibody to EA and EBDNA useful.
4. Virus isolation – Saliva, throat washings can be inoculated into umbilical cord lymphocytes. • This is time consuming and expertise needed. • This is called co-cultivation and involves - immortalitation of EBV genome into cells and leads to lympoblastoid cells. • Its presence can also be detected by fluorescent antibody staining of unclear antigen. • Others –PCR DNA hybridisation. 5. Biopsy of tumours – DNA of virus stained by specific tagged antibody.
Treatment: - • No EB vaccine. • Acyclovir reduces EBV shedding during administration. • It does not prevent immortalisation of EBV- B cells. • No use in lymphomas or IM • Adoptive transfer of EBV reactive T cell is promising treatment • For EBV associated lympho proliferative disease
• Malaria eradication associated with decreased incidence of Burkitt’s lymphoma. • Mass screening in China for Ig. A antibody to EBVAg was useful in early diagnosis of nasopharyngeal carcinoma. • 20% of Chinese with elevated Ig. A were biopsied and found to have carcinoma.
Other Herpes viruses • Human HSV-6 – Same features of HSV. • Infects dividing CD 4 + T lymphocytes. • Infected cell show ballooning with nuclear or cytoplasmic or both inclusions. • Macrophages are also infected so act as reservoir. • Isolation from saliva.
• Culture done on transformed B lymphocytes, NK cell, Glial cells, fibroblasts, epithelial cells. • Infection is asymptomatic – in immunocompromised pneumonia. • Exanthem subitum or Roseola infantum. • Mononucleosis with cervical lymphadenopathy.
Lab diagnosis: • Peripheral blood mononuclear cells – used • Isolated from the co-cultivation with cord blood lymphs • Viral Ag then detected by IF using monoclonal Ab. • PCR – to amplify viral genome. • ELISA – detect virus Ag & Ab • Virology and clinical features similar to CMV.
• HHV – 7 - Discovered is 1990. • Roseola infantum, • Also infects T lymph using same CD 4 receptor. • HSV – 8 – 1994 – Lymphotrophic rather than neurotrophic. • Kaposi sarcoma associated in HIV infected. • These people have Ab. • DNA a aplification by PCR is method of choice • 2% of general population have Ab. • Herpes B – simian virus – Occasionaly infect man • Usually fatal encephalitis.
• Occupational risk in zoo keepers and cell culture technicians. • Latent infection in monkeys. • Herpes B and HSV-1 cross react antigenically but HSV-1 does not protect from encephalitis from Herpes B. • HSV-1 Ab confuse serologically – increase in Ab titer difficult to interpret.
• Recovery of virus is specific diagnosis. • Acyclovir beneficial. • Prevention – monkey bite, mask, clothing. • Immunoglubulin containing Ab to Herpes B to be given after monkey bite • Macrophages are also infected so act as reservoir. • Isolation from saliva.